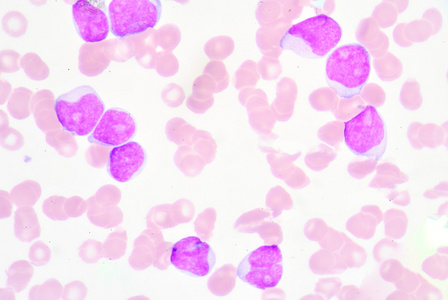
淋巴细胞增多照片

淋巴细胞图

正常淋巴细胞图6图5图4找到di筛出的异常细胞群,该群细胞胞体中等大小
图片尺寸1000x750
b淋巴细胞讲解.ppt
图片尺寸1152x864
中间的淋巴细胞是成熟的吗
图片尺寸3264x2448
淋巴细胞篇(形态)787878
图片尺寸1080x1439
淋巴细胞末图为单核细胞#显微镜下的世界 #细胞 - 抖音
图片尺寸1440x2560
淋巴细胞b细胞
图片尺寸1500x1500
异型淋巴细胞图谱
图片尺寸1174x866
颗粒淋巴细胞形态欣赏
图片尺寸750x1000
淋巴细胞
图片尺寸1100x1146
淋巴细胞增多照片
图片尺寸448x300
淋巴细胞
图片尺寸964x706
淋巴细胞
图片尺寸700x469
淋巴细胞系形态识别ppt
图片尺寸1080x810
淋巴细胞
图片尺寸1080x810
淋巴细胞lymphocyte
图片尺寸907x443
日本血液学会的异型淋巴细胞图片
图片尺寸800x600
外周血涂片#淋巴细胞白血病
图片尺寸750x1276
淋巴细胞增高,真的那么简单吗?_学术交流_检验视界_检验视界网
图片尺寸559x398
油镜下以成熟淋巴细胞为主,可见少量不典型淋巴细胞:低倍镜下骨髓增生
图片尺寸750x1000
人淋巴细胞图 (第1页) - 图说健康
图片尺寸433x331